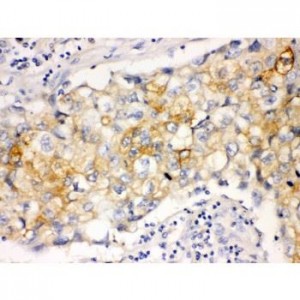
Involucrin Antibody (monoclonal)

Immunohistochemistry (IHC)
Showing 505–516 of 1068 resultsSorted by latest
-

IP3 receptor Antibody
$365.00 Add to cart -

IP10 Antibody
$330.00 Add to cart -

Ionotropic Glutamate receptor 2 Antibody
$330.00 Add to cart -
Involucrin Antibody (monoclonal)
$330.00 Add to cart -

integrin beta 4 binding protein Antibody
$330.00 Add to cart -

Integrin beta 4 Antibody
$365.00 Add to cart -

Integrin beta 3 Antibody
$330.00 Add to cart -

Integrin alpha V Antibody
$330.00 Add to cart -

Integrin alpha E Antibody
$330.00 Add to cart -

Integrin alpha 6 Antibody
$330.00 Add to cart -

Integrin alpha 4 Antibody
$365.00 Add to cart -

Integrin alpha 3 Antibody
$330.00 Add to cart